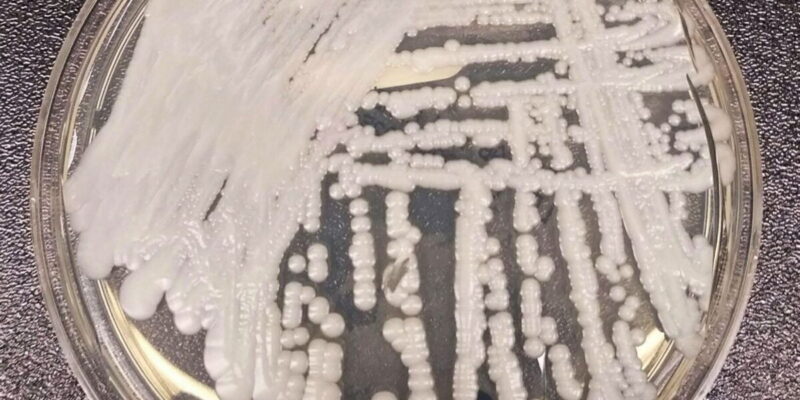

Bia Haddad luta, mas é superada por número 1 na semi de Roland Garros

Após uma campanha histórica, a brasileira Beatriz Haddad se despediu nesta quinta-feira (8) da chave de simple de Roland Garros, após ser superada pela polonesa Iga Swiatek, número um do mundo e atual campeã do torneio, por 2 sets a 0 – parciais de 6/2 e 7/6 (9-7). Apesar da derrota, a paulistana, de 27 […]
Gripe aviária: Espírito Santo proíbe turistas em ilhas de Vitória

O governo do Espírito Santo proibiu, por tempo indeterminado, o acesso ao Arquipélago das Três Ilhas e às demais ilhas da Área de Proteção Ambiental (APA) de Setiba, localizada nos municípios de Guarapari e Vila Velha, região metropolitana de Vitória. A medida foi adotada em razão dos casos de gripe aviária registrados no estado e […]
Maratona do Rio reunirá 40 mil participantes em dois dias de provas

A 21ª edição da Maratona do Rio no feriadão de Corpus Christi vai reunir 40 mil atletas profissionais e amadores, nas cinco provas que serão disputadas em dois dias. No sábado (10) estarão nas pistas os corredores da prova de 5 quilômetros, que é a mais curta. Além deles, vão participar no mesmo dia os […]
Anvisa revoga ações preventivas aplicadas a produtos da Fugini

A Agência Nacional de Vigilância Sanitária (Anvisa) revogou, nessa quarta-feira (7), medidas de fiscalização sanitária abrangendo a empresa Fugini Alimentos Ltda. Localizada na cidade de Monte Alto (SP), a empresa teve seus produtos suspensos em março deste ano, após inspeção sanitária com resultado insatisfatório. Em abril, após adequações e reformas em seus procedimentos internos, a […]
São Paulo confirma primeiro caso de superfungo Candida auris
O estado de São Paulo confirmou o seu primeiro caso do superfungo Candida auris em um paciente neonatal do Hospital da Mulher Prof. Dr. José Aristodemo Pinotti, da Unicamp (Universidade Estadual de Campinas), na cidade de Campinas. De acordo com informações da Secretaria de Saúde, a presença do fungo foi detectada no dia 18 de […]
Brasil e Argentina duelam pela Liga das Nações de vôlei masculino

A seleção masculina de vôlei terá um clássico sul-americano pela frente na segunda rodada da Liga das Nações. Nesta quinta-feira (8), às 21h (horário de Brasília), os brasileiros enfrentam a Argentina, em Ottawa (Canadá). O último jogo entre os rivais ocorreu nas quartas de final do Campeonato Mundial do ano passado, em Gliwice (Polônia), com triunfo […]
MEC divulga cronogramas do Sisu, Prouni e Fies

O Ministério da Educação (MEC) divulgou os editais com os cronogramas dos processos seletivos para o segundo semestre de 2023 do Sistema de Seleção Unificada (Sisu), Programa Universidade para Todos (Prouni) e Fundo de Financiamento Estudantil (Fies). Os documentos foram publicados na edição de quarta-feira (7) do Diário Oficial da União. Em datas próximas às […]
Pacote automotivo: especialista elogia programa, mas questiona prazo

[ Anunciado nesta semana como medida de socorro ao setor automotivo, o pacote que barateia temporariamente a compra de carros, ônibus e caminhões pode não surtir o efeito esperado sobre a indústria. Segundo especialistas, a curta duração e o volume de recursos do programa de ajuda podem resultar num alcance limitado, que pouco mudará a […]
Arthur Zanetti destaca estratégia em último ciclo olímpico da carreira

A etapa de Osijek (Croácia) da Copa do Mundo de ginástica artística, que começa nesta quinta-feira (8), marca o retorno de Arthur Zanetti às competições internacionais quase um ano após vencer o Campeonato Pan-Americano, no Rio de Janeiro. Aos 35 anos, o campeão olímpico das argolas nos Jogos de Londres (Grã-Bretanha), em 2012, e prata […]
Flamengo recebe Racing no Maracanã de olho nas oitavas da Libertadores

Tentando encaminhar a vaga para as oitavas de final da Copa Libertadores, o Flamengo recebe o Racing (Argentina), a partir das 21h (horário de Brasília) desta quinta-feira (8) no estádio do Maracanã, pela 5ª rodada do Grupo A da competição continental. A Rádio Nacional transmite o jogo decisivo ao vivo. Vivendo uma boa fase, a […]